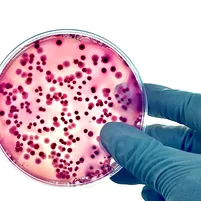

Handling food safely
Keeping it fresh. Food safety best practices
Your food is safe when it’s fresh and properly handled. European and national rules backed by science support farmers, businesses, restaurants, and you the consumer in ensuring your daily meal is safe to eat.
How you handle food matters. From shopping to cooking to dining there are tips you can follow on safe storage, cooking practices, and kitchen hygiene to help you play your part in food safety.
These tips are backed by the latest science. European scientists evaluate the potential risks of food ingredients and foodborne diseases, so authorities can inform you how to reduce risks while being free to choose the food you prefer.
Food labels are one source of help. They tell you the shelf life of fresh foods, and the nutritional content of processed foods. You can consider this information alongside the other things that matter to you such as the taste, cost, or reducing food waste.